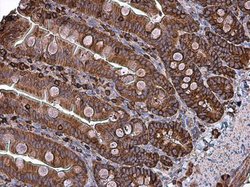
Invitrogen Coronin 1A Polyclonal Antibody 100 &mu;L; Unconjugated:Antibodies,

missing translation for 'onlineSavingsMsg'
Learn More
Learn More
Invitrogen™ Coronin 1A Polyclonal Antibody


Rabbit Polyclonal Antibody
Brand: Invitrogen™ PA528450
This item is not returnable.
View return policy
Description
Recommended positive controls: U87-MG, SK-N-SH, IMR32, SK-N-AS. Predicted reactivity: Bovine (100%). Store product as a concentrated solution. Centrifuge briefly prior to opening the vial.
This gene encodes a member of the WD repeat protein family. WD repeats are minimally conserved regions of approximately 40 amino acids typically bracketed by gly-his and trp-asp (GH-WD), which may facilitate formation of heterotrimeric or multiprotein complexes. Members of this family are involved in a variety of cellular processes, including cell cycle progression, signal transduction, apoptosis, and gene regulation. Alternative splicing results in multiple transcript variants. A related pseudogene has been defined on chromosome 16.
Specifications
| Coronin 1A | |
| Polyclonal | |
| Unconjugated | |
| CORO1A | |
| actin-binding; bovine p57; Clabp; Clabp coronin; CLIPINA; Clipin-A; CORO1; CORO1A; CORO1A protein; coronin 1; coronin 1A; coronin, actin binding protein 1A; coronin, actin binding protein, 1A; coronin-1; coronin-1A; coronin-like actin binding protein; coronin-like protein A; Coronin-like protein p57; FLJ41407; HCORO1; IMD8; Lmb3; MGC117380; p57; TACO; tryptophan aspartate-containing coat protein | |
| Rabbit | |
| Antigen affinity chromatography | |
| RUO | |
| 11151, 12721, 155151 | |
| Store at 4°C short term. For long term storage, store at -20°C, avoiding freeze/thaw cycles. | |
| Liquid |
| Immunohistochemistry (Frozen), Immunohistochemistry (Paraffin), Western Blot, Immunocytochemistry | |
| 1 mg/mL | |
| 0.1M tris glycine with 10% glycerol and 0.01% thimerosal; pH 7 | |
| O89053, P31146, Q91ZN1 | |
| CORO1A | |
| Carrier-protein conjugated synthetic peptide encompassing a sequence within the C-terminus region of human Coronin 1A. The exact sequence is proprietary. | |
| 100 μL | |
| Primary | |
| Human, Mouse, Rat | |
| Antibody | |
| IgG |
Product Content Correction
Your input is important to us. Please complete this form to provide feedback related to the content on this product.
Product Title
Spot an opportunity for improvement?Share a Content Correction